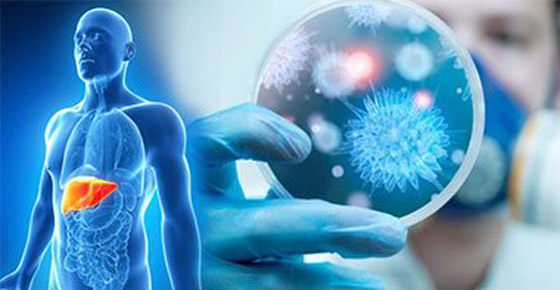
كيف يؤثر فيروس كورونا على الكبد؟.. هذا سر وفاة الأصحاء! صورة رقم 1 كيف يؤثر فيروس كورونا على الكبد؟.. هذا سر وفاة الأصحاء! صورة رقم 1

كيف يؤثر فيروس كورونا على الكبد؟.. هذا سر وفاة الأصحاء!
أكدت دراسة قام به علماء أميركيون على أن فيروس كورونا المستجد يقوم بعد مهاجمة الرئتين بالتوجه إلى عضلة القلب، ويمكن أن يتلفها حتى لدى الأفراد الذين لا يعانون من أي أمراض قلبية كامنة. ونشرت صحيفة بريطانية تقريراً عن الدراسة المهمة كشفت فيه أن Covid-19 يمكن أن يكون له عواقب وخيمة على الأفراد، الذين يعانون من أمراض القلب والأوعية الدموية، الموجودة مسبقا مثل ارتفاع ضغط الدم.
وأكد الدكتور محمد مجيد، رئيس المجموعة العلمية التي قامت بالدراسة والأستاذ المساعد لأمراض القلب في كلية الطب بمركز العلوم الصحية بجامعة تكساس في هيوستن على أنه حتى في غياب أمراض القلب السابقة، يمكن أن تتأثر عضلة القلب بفيروس كورونا ولكن بالطبع التأثير يكون أكبر لدى من يعانون بالفعل من مشاكل في القلب.
أسوأ أزمة عالمية منذ نهاية الحرب العالمية الثانية
واعتبر الأمين العام للأمم المتّحدة أنطونيو غوتيريس، الأربعاء، أن جائحة كوفيد-19 هي أسوأ أزمة عالمية منذ نهاية الحرب العالمية الثانية قبل 75 عاماً، معرباً عن قلقه من أن تتسبّب تداعياتها بتأجيج النزاعات والحروب في العالم. وقال غوتيتريس، في لقاء مع عدد من الوسائل الإعلامية، إن فيروس كورونا المستجدّ الذي ظهر في الصين في نهاية العام الماضي واستحال وباء عالمياً هو "أسوأ أزمة عالمية منذ تأسيس الأمم المتحدة" في 1945.
وأوضح أن السبب في ذلك هو أنّ هذه الجائحة "يجتمع فيها عنصران: الأول هو أنّها مرض يمثّل تهديداً للجميع في العالم، والثاني هو أن تأثيرها الاقتصادي سيؤدّي إلى ركود لعلّنا لم نرَ مثيلاً له في الماضي القريب". وأضاف أنّ "اجتماع هذين العنصرين وخطر حصول اضطرابات عميقة وأعمال عنف متزايدة ونزاعات متصاعدة هي أمور تجعلنا نعتقد أن هذه هي بالفعل الأزمة الأكثر صعوبة التي نواجهها منذ الحرب العالمية الثانية". وشدّد الأمين العام على أن هذه الأزمة تستدعي من البشرية جمعاء التضامن ووضع الخلافات جانباً. وقال "نحتاج إلى استجابة أقوى وأكثر فعالية لا يمكن أن تتحقق إلا إذا تضامنّا جميعاً ونسينا الألاعيب السياسية ووعينا أن البشرية بأسرها على المحكّ".

كيف يؤثر فيروس كورونا على الكبد؟
تتواصل الجهود البحثية التي يبذلها العلماء في كل مكان بغية التعرف أكثر على فيروس كورونا المستجد ومن ثم الاقتراب من تطوير أدوية أو لقاحات تحد من انتشاره. ومن ضمن هذه الجهود تلك التي يقوم بها باحثون صينيون، وتوصلوا من خلالها لبيانات جديدة تبين أن وباء "كوفيد-19" قد يخلف آثارا ضارة بالكبد والجهاز الهضمي.
وقال الباحثون إنه وبالرغم من أن الأعراض التنفسية هي أكثر أعراض الوباء شيوعا وظهورا، غير أنها ليست الأعراض المبكرة الوحيدة الدالة على الإصابة بالفيروس، فالإسهال، الغثيان، التقيؤ ووجع البطن كلها أعراض تم توثيقها بشكل جيد، وغالبا ما تسبق الأعراض التنفسية، كما اتضح من ملاحظات الباحثين في دراستهم التي شملت 138 مريضا في احدى المستشفيات في مدينة ووهان الصينية.

كما أشارت دراسة نشرت مؤخرا إلى اكتشاف فيروس كورونا المستجد في براز أكثر من 50 % من المرضى المصابين المقيمين بالمستشفى. وإلى جانب ذلك، اكتشف الباحثون أن الكبد يصاب بحالة من الضعف عند الإصابة بـ "كوفيد-19"، تماما كما كان الحال عند الإصابة بمرض "سارس"، حيث أظهر تقرير بحثي نشر عام 2004 أن 60 % من مرضى "سارس" عانوا من ضعف بوظائف الكبد بعد إصابتهم.
وأوضح الباحثون أن إصابة هؤلاء المرضى بضعف في وظائف الكبد لديهم ربما نتجت عن معالجتهم ببعض الأدوية، بالنظر إلى أن معظمهم قد تمت معالجتهم بجرعات عالية من مضادات الفيروسات المزمنة، المضادات الحيوية والستيرويدات. وتابع الباحثون بقولهم إن الأشخاص الذين يكونون أكثر عرضة للإصابة بحالات "كوفيد-19" الحادة هم عادة الأشخاص كبار السن و/أو الأشخاص الذين يعانون من أمراض مصاحبة مثل مرض السكري، أمراض القلب والأوعية الدموية وارتفاع ضغط الدم.

وهو نفس الأمر بالنسبة لهؤلاء الأشخاص المعرضين بشكل متزايد لخطر الإصابة بأمراض الكبد الأساسية غير المعروفة، وخصوصا مرض الكبد الدهني غير الكحولي. فذلك قد يجعلهم أكثر عرضة لإصابة الكبد نتيجة الفيروس، الأدوية المستخدمة في الإدارة الداعمة أو نقص الأكسجة.
كما أنه من المعروف أن أنزيمات الكبد ترتفع أثناء الالتهابات الجهازية، وأن الانفلونزا الموسمية لا تتسبب في حدوث التهاب بالكبد. ومن ثم يجب التعامل بكل حيطة وحذر مع الأشخاص الذين قد يكون لديهم مشكلات بالكبد أو الجهاز الهضمي عند الاشتباه في إصابتهم بـ "كوفيد-19"، حيث يجب اختبارهم ومن ثم عزلهم لحين التأكد من نتائج اختباراتهم.







 للتواصل معنا
للتواصل معنا 